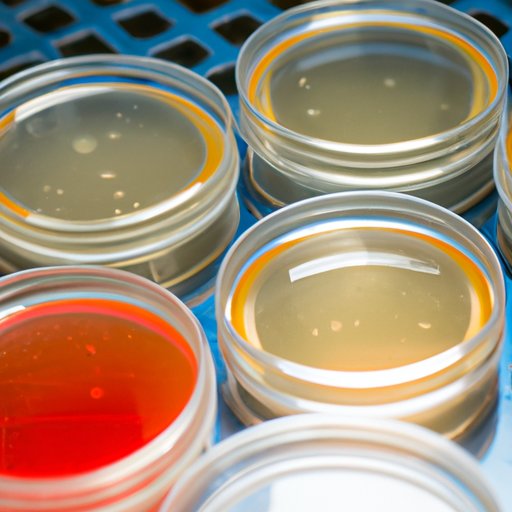

Introduction
Liquid culture is a method of culturing microorganisms in a nutrient-rich liquid medium. It is used in a variety of scientific fields, such as microbiology, biotechnology, and genetic engineering, to study the growth and behavior of living organisms. This article will provide a comprehensive guide to making liquid culture, from gathering the necessary materials to monitoring growth and adjusting conditions as needed.
Step-by-Step Guide to Making Liquid Culture
Creating a successful liquid culture requires careful attention to detail and precise measurements. The following steps should be followed when making liquid culture:
Gather Necessary Materials
The first step in making liquid culture is to gather all of the necessary materials. These include a container, such as a flask or bottle; nutrient media (such as broth or agar); an inoculum (a sample of the organism to be cultured); a pH buffer; and a thermometer.
Prepare the Nutrient Media
The next step is to prepare the nutrient media. This involves measuring out the correct amount of each ingredient and mixing them together until they are thoroughly combined. Depending on the type of media being used, additional ingredients may be required. For example, if using a broth-based media, it may need to be supplemented with vitamins, minerals, and other nutrients.
Sterilize the Media and Container
Once the media has been prepared, it must be sterilized to ensure that no contamination occurs during the culturing process. This can be done by boiling the media for at least 15 minutes or by using a pressure cooker. The container should also be sterilized before use.
Inoculate the Media
The next step is to inoculate the media with the inoculum. This can be done by adding a small amount of the inoculum to the media and stirring it in. Care should be taken to avoid contamination when handling the inoculum.
Monitor Growth and Adjust Conditions as Needed
Once the inoculum has been added, the culture should be monitored closely. The temperature and pH levels should be checked regularly and adjusted as needed. The growth of the culture should also be monitored and any changes noted.

How to Create a Perfect Liquid Culture for Your Lab
Creating a perfect liquid culture for your laboratory requires careful consideration of several factors. Here are some tips for creating a quality liquid culture:
Choose the Right Nutrient Media
The type of nutrient media used will have a major impact on the success of the culture. Different types of media are available for different purposes, so it is important to select the right one for your needs. For example, if you are culturing bacteria, a nutrient broth would be more suitable than an agar plate.
Monitor pH Levels and Temperature
Maintaining the proper pH level and temperature is essential for creating a successful liquid culture. The pH level should be checked regularly and adjusted as needed. The temperature should also be monitored and kept within the optimal range for the organism being cultured.
Use Appropriate Inoculation Techniques
When inoculating the media, it is important to take precautions to avoid contamination. This includes wearing gloves and using aseptic techniques when transferring the inoculum to the media. Additionally, it is important to use the correct amount of inoculum to ensure that the culture grows properly.

Tips for Making a Quality Liquid Culture
Making a quality liquid culture requires attention to detail and a commitment to following best practices. Here are some tips for ensuring the success of your liquid culture:
Ensure Sterility of All Materials
It is essential to ensure that all materials used in the culturing process are sterile. This includes the media, container, and inoculum. This can be done by boiling the materials or using a pressure cooker.
Label Containers Accurately
Labelling containers accurately is important to ensure that the culture is not contaminated. All containers should be clearly labelled with the date, media type, and organism being cultured.
Maintain Proper Incubation Conditions
To ensure the success of the culture, it is important to maintain the proper incubation conditions. This includes maintaining the correct temperature and pH levels, as well as providing adequate oxygen to the culture.
A Beginner’s Guide to Making Liquid Culture
Making liquid culture can be daunting for a beginner, but with the right guidance and resources, it can be a relatively straightforward process. Here are some tips for those just starting out:
Understand the Basic Requirements for Creating a Successful Liquid Culture
It is important to understand the basic requirements for creating a successful liquid culture. This includes having the correct materials, preparing the media properly, and monitoring the conditions of the culture.
Follow Step-by-Step Instructions Carefully
When making liquid culture, it is important to follow the instructions carefully. This includes measuring the ingredients accurately and sterilizing the materials correctly. Even small mistakes can have a big impact on the success of the culture.
Seek Help From Experienced Professionals If Needed
If you are new to making liquid culture, it is recommended that you seek help from experienced professionals. They can provide valuable advice and support throughout the process, helping you to create a successful liquid culture.

The Essential Ingredients for Making Liquid Culture
Successfully making liquid culture requires a few essential ingredients. These include:
Nutrient Media
Nutrient media is the primary ingredient in a liquid culture. Different types of media are available, such as broth, agar, and solidified media. The type of media chosen will depend on the purpose of the culture.
Inoculum
Inoculum is a sample of the organism to be cultured. It can be obtained from a variety of sources, such as another culture or from a sample of soil, water, or air.
pH Buffer
A pH buffer is used to maintain the correct pH level for the culture. Different buffers are available, such as boric acid, sodium bicarbonate, and potassium phosphate.
Agar
Agar is a gelatinous substance used to solidify liquid media. It is often used in combination with broth or other media to create a solid medium for culturing organisms.
What You Need to Know Before Making Liquid Culture
Before making liquid culture, it is important to understand the basics of culturing microorganisms. This includes knowing the appropriate safety protocols, sterilization methods, and different types of media available.
Basic Safety Protocols
When making liquid culture, it is important to follow safety protocols to avoid contamination. This includes wearing gloves and using aseptic techniques when handling the inoculum and media. Additionally, all materials should be sterilized before use.
Appropriate Sterilization Methods
Sterilizing the materials used in liquid culture is essential to avoid contamination. This can be done by boiling the media for at least 15 minutes or by using a pressure cooker. The container should also be sterilized before use.
Different Types of Media Available
There are a variety of media available for culturing microorganisms, such as broth, agar, and solidified media. The type of media chosen will depend on the purpose of the culture and the organism being cultured.
Conclusion
Making liquid culture requires attention to detail and precise measurements. This article provided a comprehensive guide to making liquid culture, from gathering the necessary materials to understanding safety protocols. By following the steps outlined in this article, you can successfully create a perfect liquid culture for your laboratory. Remember to choose the right nutrient media, monitor pH levels and temperature, use appropriate inoculation techniques, ensure sterility of all materials, label containers accurately, and maintain proper incubation conditions for a successful liquid culture.
(Note: Is this article not meeting your expectations? Do you have knowledge or insights to share? Unlock new opportunities and expand your reach by joining our authors team. Click Registration to join us and share your expertise with our readers.)